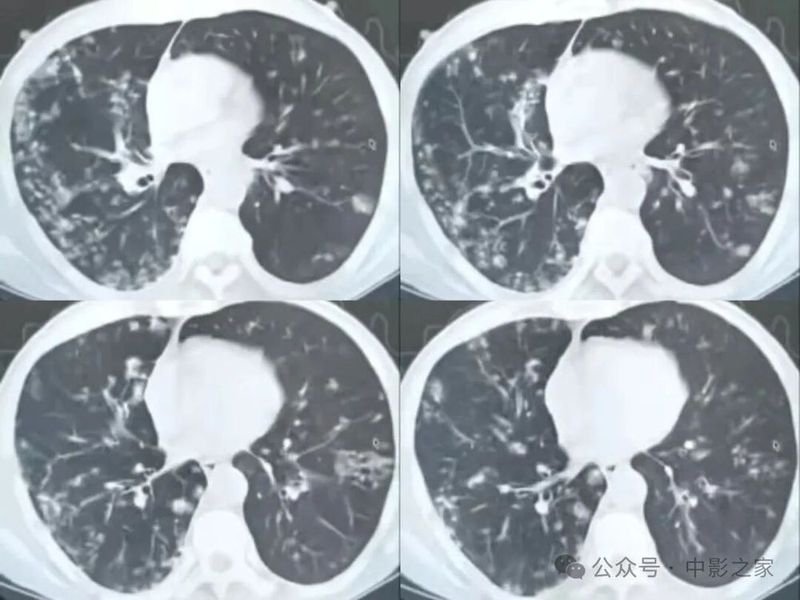
图片

肿瘤患者,肺内病灶抗炎治疗10多天无好转

诊断:肺结核
一、概述
“烟花征”,为活动性肺结核的CT表现之一。是结核经支气管播散并由多发小叶中央结节堆积而成,形态特征似烟花在空中散开。病理基础为细支气管及肺泡内干酪坏死性肉芽肿。
一般分为3类
1、晕征样(中央修复为主);

2、反晕征样(边缘修复为主);

3、均自样(均自修复);

三类有时候无明确分界,可以同时存在各类表现,或分界不清。
二、分类
1、中央修复为主

2、边缘修复为主

3、均匀修复型

三、影像表现
1.多形态、多部位


2、天女散花

3、晕征

4、反晕征

5、可伴有空洞

四、总结
“烟花征”多是结核支气管播散的表现
影像上为小结节的聚集,病理上为肉芽肿性结节
可单发,可多发,可伴有空洞
影像表现形式多种多样
'烟花征”是活动性肺结核的表现
